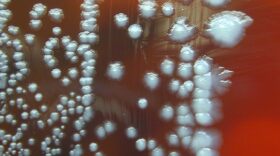

Laurel Morales
Senior Field CorrespondentSenior Field Correspondent Laurel Morales (Flagstaff) has been a public radio reporter for 10 years; eight of them in Arizona. She has won several awards for her work, including national recognition from Public Radio News Director Inc. (PRNDI) for the only commentary she’s ever written. She prefers to highlight compelling voices other than her own and has covered blizzards, wildfires, floods and tornadoes. Morales came to northern Arizona from rural Minnesota where she worked as a reporter after receiving her master’s degree from Northwestern University’s Medill School of Journalism.
MORE STORIES BY THIS AUTHOR
-
Schools in Indian Country are starting to feel the effects of across-the-board federal budget cuts known as sequestration. For the Navajo Nation that means larger class sizes, putting off building repairs and fewer buses — which is a big deal where children travel up to 70 miles to get to school.
-
John Rosenow is a fifth-generation dairy farmer, but times have changed since his Norwegian ancestors began farming in Cochrane, Wis. And Rosenow has changed with the times. Much of his workforce is now from Mexico, and Rosenow travels regularly to their village in southern Mexico to meet their families.
-
Federal officials are preparing for the worst this fire season. Severe drought conditions and beetle ravaged trees throughout the west combined with reduced firefighting budgets do not bode well for the coming weeks.
-
Northern Arizona University biologists have pinpointed the source of one of the deadliest plagues of all time. The discovery not only solves some ancient mysteries about the first pandemic, but could also provide answers in the event of a bioterrorism threat.
-
The Grand Canyon National Park and other federal agencies are going to great lengths to save a homely fish in the Colorado River Basin. The latest: translocation, which involves several trucks, helicopters and biologists.
-
Latinos have called both the rural and urban Southwest home for generations. But much of the rest of the nation is now adjusting to the latest wave of immigrants from Mexico and Latin America.
- Parents push Encinitas to act after daughter’s crosswalk death
- As ridership grows, MTS seeks input on looming 'fiscal cliff'
- Arrest near a South Bay high school is latest in a string of immigration enforcements close to schools
- Heat wave peaking Friday; cooling, chances of showers expected this weekend
- What about Texas? California Republicans pressed for answers in redistricting fight